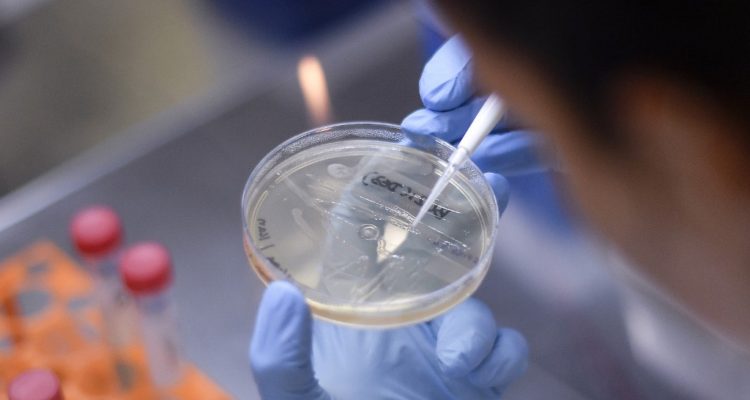
ARCHIVO | AFP

El regulador sanitario de Brasil anunció haber suspendido los ensayos clínicos de una vacuna china contra el covid-19 después de que un voluntario sufriera “un incidente grave”.
La Agencia de Vigilancia Sanitaria (Anvisa) brasileña “decidió interrumpir el ensayo clínico de la vacuna CoronaVac tras un incidente grave” el 29 de octubre.
El organismo no dio detalles sobre lo ocurrido, pero indicó que esos incidentes podían incluir la muerte, efectos secundarios posiblemente fatales, una discapacidad grave, una hospitalización y otros “acontecimientos clínicamente significativos”.
A la espera de más precisiones sobre lo ocurrido, el laboratorio chino Sinovac Biotech se dijo este martes “confiado” en la seguridad de su vacuna.
“Estamos confiados en la seguridad de la vacuna”, declaró Sinovac en un comunicado en el que afirmó que el incidente en cuestión no tenía “relación” con la vacuna.
El organismo público que coordina los ensayos de la vacuna en Brasil, el Instituto Butantan, se mostró “sorprendido” por la suspensión de los ensayos.
El instituto “está investigando en detalle lo que ocurrió” y “está a disposición de la agencia reguladora brasileña para aportar toda aclaración necesaria sobre cualquier incidente que pudo ocurrir en los ensayos clínicos”, añadió. El martes dará una rueda de prensa sobre este tema a las 11:00.
CoronaVac ha sido el centro de una batalla política en Brasil entre uno de sus mayores defensores en el país, el gobernador de Sao Paulo, Joao Doria, y su principal rival político, el presidente Jair Bolsonaro.
El gobierno del estado de Sao Paulo dijo en un comunicado que “lamenta haber tenido conocimiento de la decisión por la prensa, en lugar de hacerlo directamente por Anvisa”, y esperaba junto con el Instituto Butantan más información sobre “las verdaderas razones de la suspensión”.
Pandemia y política
El mandatario ultraderechista se ha referido al modelo de Sinovac como la vacuna de “ese otro país” y ha promovido en su lugar la que está desarrollando la Universidad de Oxford con la compañía farmacéutica británica AstraZeneca.
El mes pasado, Bolsonaro canceló un acuerdo de compra de 46 millones de dosis de la vacuna china que había anunciado su propio ministro de Salud.
“El pueblo brasileño no será el conejillo de indias de nadie”, dijo Bolsonaro, quien se refirió al proyecto como “la vacuna china de Joao Doria”.
Horas antes de que se anunciara la suspensión de los ensayos, Doria había indicado que las primeras 120.000 dosis de CoronaVac iban a llegar a Sao Paulo el 20 de noviembre.
Su estado tiene un acuerdo con Sinovac para adquirir 46 millones de dosis, seis millones producidas en China y el resto, en Sao Paulo.
“Los funcionarios del gobierno estatal temen que Bolsonaro utilice decisiones técnicas para retrasar el cronograma de la vacuna por razones políticas”, informó el diario Folha de Sao Paulo, citando aliados de Doria.
El contratiempo para CoronaVac llegó el mismo día en que el gigante farmacéutico estadounidense Pfizer anunció que su vacuna contra el coronavirus tiene un 90% de efectividad.
Las vacunas de Pfizer y Sinovac se encuentran en la fase 3 de los ensayos, la última antes de obtener o no el visto bueno de las autoridades reguladoras.
Ambas se están probando en Brasil, el país con el segundo mayor número de muertos por covid-19 por detrás de Estados Unidos, con más de 162.000 fallecidos.







 Enviando corrección, espere un momento...
Enviando corrección, espere un momento...